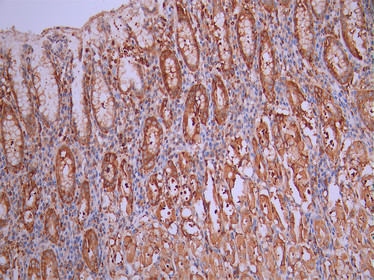

DIAPH1 Recombinant Monoclonal Antibody
-
中文名稱:DIAPH1 Recombinant Monoclonal Antibody
-
貨號:CSB-RA080723A0HU
-
規(guī)格:¥1320
-
圖片:
-
Western Blot
Positive WB detected in: MCF7 whole cell lysate(30μg), A431 whole cell lysate(30μg)
All lanes: Diaphanous homolog 1 antibody at 1:1000
Secondary
Goat polyclonal to rabbit IgG at 1/40000 dilution
Predicted band size: 141 kDa
Observed band size: 150 kDa
Exposure time:2min -
IHC image of CSB-RA080723A0HU diluted at 1:100 and staining in paraffin-embedded human stomach tissue performed on a Leica BondTM system. After dewaxing and hydration, antigen retrieval was mediated by high pressure in a citrate buffer (pH 6.0). Section was blocked with 10% normal goat serum 30min at RT. Then primary antibody (1% BSA) was incubated at 4°C overnight. The primary is detected by a Goat anti-rabbit polymer IgG labeled by HRP and visualized using 0.05% DAB.
-
IHC image of CSB-RA080723A0HU diluted at 1:100 and staining in paraffin-embedded human liver cancer performed on a Leica BondTM system. After dewaxing and hydration, antigen retrieval was mediated by high pressure in a citrate buffer (pH 6.0). Section was blocked with 10% normal goat serum 30min at RT. Then primary antibody (1% BSA) was incubated at 4°C overnight. The primary is detected by a Goat anti-rabbit polymer IgG labeled by HRP and visualized using 0.05% DAB.
-
Overlay Peak curve showing Hela cells stained with CSB-RA080723A0HU (red line) at 1:100. The cells were fixed in 4% formaldehyde and permeated by 0.2% TritonX-100 for 10min. Then 10% normal goat serum to block non-specific protein-protein interactions followed by the antibody (1ug/1*106cells) for 45min at 4℃. The secondary antibody used was FITC-conjugated goat anti-rabbit IgG (H+L) at 1/200 dilution for 35min at 4℃.Control antibody (green line) was Rabbit IgG (1ug/1*106cells) used under the same conditions. Acquisition of >10, 000 events was performed.
-
-
其他:
產品詳情
-
Uniprot No.:
-
基因名:
-
別名:DIAPH1 antibody; deafness; autosomal dominant 1 antibody; DFNA1 antibody; DIA1 antibody; DIAP1 antibody; DIAP1_HUMAN antibody; DIAPH1 antibody; Diaphanous homolog 1 (Drosophila) antibody; diaphanous homolog 1 antibody; Diaphanous related formin 1 antibody; Diaphanous-related formin-1 antibody; DRF1 antibody; FLJ25265 antibody; hDIA1 antibody; LFHL1 antibody; low frequency hearing loss 1 antibody; p140DIA antibody; Protein diaphanous homolog 1 antibody
-
反應種屬:Human
-
免疫原:A synthesized peptide from human DIAPH1 protein
-
免疫原種屬:Homo sapiens (Human)
-
標記方式:Non-conjugated
-
克隆類型:Monoclonal
-
抗體亞型:Rabbit IgG
-
純化方式:Affinity-chromatography
-
克隆號:20F8
-
濃度:It differs from different batches. Please contact us to confirm it.
-
保存緩沖液:Rabbit IgG in 10mM phosphate buffered saline , pH 7.4, 150mM sodium chloride, 0.05% BSA, 0.02% sodium azide and 50% glycerol.
-
產品提供形式:Liquid
-
應用范圍:ELISA, WB, IHC, FC
-
推薦稀釋比:
Application Recommended Dilution WB 1:500-1:5000 IHC 1:50-1:200 FC 1:50-1:200 -
Protocols:
-
儲存條件:Upon receipt, store at -20°C or -80°C. Avoid repeated freeze.
-
貨期:Basically, we can dispatch the products out in 1-3 working days after receiving your orders. Delivery time maybe differs from different purchasing way or location, please kindly consult your local distributors for specific delivery time.
-
用途:For Research Use Only. Not for use in diagnostic or therapeutic procedures.
相關產品
靶點詳情
-
功能:Actin nucleation and elongation factor required for the assembly of F-actin structures, such as actin cables and stress fibers. Binds to the barbed end of the actin filament and slows down actin polymerization and depolymerization. Required for cytokinesis, and transcriptional activation of the serum response factor. DFR proteins couple Rho and Src tyrosine kinase during signaling and the regulation of actin dynamics. Functions as a scaffold protein for MAPRE1 and APC to stabilize microtubules and promote cell migration. Has neurite outgrowth promoting activity. Acts in a Rho-dependent manner to recruit PFY1 to the membrane. In hear cells, it may play a role in the regulation of actin polymerization in hair cells. The MEMO1-RHOA-DIAPH1 signaling pathway plays an important role in ERBB2-dependent stabilization of microtubules at the cell cortex. It controls the localization of APC and CLASP2 to the cell membrane, via the regulation of GSK3B activity. In turn, membrane-bound APC allows the localization of the MACF1 to the cell membrane, which is required for microtubule capture and stabilization. Plays a role in the regulation of cell morphology and cytoskeletal organization. Required in the control of cell shape. Plays a role in brain development. Also acts as an actin nucleation and elongation factor in the nucleus by promoting nuclear actin polymerization inside the nucleus to drive serum-dependent SRF-MRTFA activity.
-
基因功能參考文獻:
- Diaph1 is highly expressed in glioma, plays a significant role in glioma cell migration, and can influence the expression and activity of MMP2 and MMP9. PMID: 29035824
- The aim of this study was to investigate the role of DIAPH1 in the physiological response to experimental myocardial I/R in mice. After subjecting wild-type mice to experimental I/R, myocardial DIAPH1 expression was increased, an effect that was echoed following hypoxia/reoxygenation (H/R) in H9C2 and AC16 cells PMID: 29239839
- Data show that diaphanous related formin 1 protein (Dia1) and diaphanous related formin 2 protein (Dia2) facilitated HIV-1-induced microtubule (MT) stabilization and the intracellular motility of virus particles. PMID: 28760985
- Down-regulation of mDia1 by infection with an adenovirus encoding siRNA or blockade of RAGE-mDia1 binding by transfection with RAGE mutant plasmids into HUVECs abolished these AGE-induced effects. PMID: 29490301
- DIAPH1 mutation is associated with Progressive macrothrombocytopenia and hearing loss. PMID: 28815995
- It is therefore noteworthy that we found DIAPH1 expression also in spiral ganglion neurons and in the barrier between the myelinating glia of the peripheral nervous system and oligodendrocytes that form the myelinating glia of the central nervous system (CNS). PMID: 27808407
- mDia1 was recruited to the zonula adherens (ZA) of established Caco-2 monolayers in response to E-cadherin and RhoA. PMID: 28329679
- Actin dynamics and formins control DNA replication by multiple direct and indirect mechanisms. PMID: 28982779
- DIAPH1 interaction with the RAGE cytoplasmic domain. [review] PMID: 27967251
- Ligand-induced association of RAGE homodimers on the cell surface increases the molecular dimension of the receptor, recruiting DIAPH1 and activating signaling pathways. PMID: 27524199
- The authors describe a novel patient-derived DIAPH1 mutation (c.3610C>T) in two unrelated families, which results in early termination prior to a basic amino acid motif (RRKR(1204-1207)) at the DAD C-terminus. The mutant DIA1(R1204X) disrupted the autoinhibitory DID-DAD interaction and was constitutively active. PMID: 27707755
- The description of a novel disorder of platelet formation and hearing loss extends the repertoire of DIAPH1-related disease, and provides new insight into the autoregulation of DIAPH1 activity. PMID: 26912466
- Studies indicate that diaphanous related formin 1 (DIAPH1) is essentially involved in microtubules (MTs)-dependent early adhesion of colon cancer cells. PMID: 27911711
- A 51-year-old patient in a Korean family with ADNSHL was examined by pure-tone audiometry, and genetic analysis of DIAPH1 was performed. A novel variant, p.I530S (c.1589T > G), was identified in the DIAPH1 gene, and the mutation was located in the highly conserved coiled-coil domain of the DIA1 protein. PMID: 28003573
- mDia1 is an important regulator of breast cancer cell invasion and that its effects may be mediated by MMP-2 activity. PMID: 27177153
- Findings suggest that regulation of cellular trafficking and microtubule-mediated localization of MT1-MMP by mDia1 is likely important in breast cancer invasion through the expression of cancer stem cell genes. PMID: 26893363
- Loss-of-function variants in DIAPH1 is associated with syndromic microcephaly, blindness, and early onset seizures. PMID: 26463574
- functional complementation experiments and optogenetics to show that mDia1 cooperates with the Arp2/3 complex in initiating lamellipodia and ruffles. PMID: 26349808
- Capping protein and dia1 functionally coregulate filament barbed-end assembly. PMID: 26564775
- mDia1 displaced from the barbed end by CapZ Actin Capping Protein can randomly slide along the actin filament and later return. PMID: 26566078
- Data indicate that diaphanous homolog 1 (Drosophila) protein (DIAPH1) stabilizes microtubules and reduces microtubule dynamics. PMID: 26124177
- The Rho-mDia1 signaling pathway is involved in the cytoskeletal rearrangement of human periodontal ligament cells induced by cyclic strain. PMID: 26201082
- Patients with a homozygous nonsense DIAPH1 alteration (p.Gln778*) have MCP as well as reduced height and weight. PMID: 24781755
- the RhoA-regulated formin Dia1 is involved in entosis downstream of LPAR2 PMID: 24950964
- DIAPH1 has a critical role in generating F-actin structures and assisting the microtubule stabilization underlying proplatelet formation and platelet production PMID: 25298036
- Dia1, Dia2, and Dia3 are involved in ErbB2-dependent capture of microtubules at the cell leading edge and ErbB2-driven guided migration. PMID: 24403606
- Mechanistically, mDia1 deficiency led to a downregulation of membrane-associated genes and a specific upregulation of CD14 messenger RNA in granulocytes, but not in other lineages. PMID: 24891322
- The results revealed that treatment with siRNA-mDRF1 significantly inhibited tumor growth and led to a decrease in the weight of the transplanted tumor. In conclusion, our data demonstrate that mDRF1 is highly expressed in human glioma tissue. PMID: 24317603
- Depletion of DIAPH1 reduced metastasis 60-fold. PMID: 24105619
- Recruitment of Syx to the cell membrane, the selective activation of Dia1 signaling, coupled with the suppression of ROCK and actin reorganization, plays a key role in establishing cell polarity during directed cell migration. PMID: 24126053
- findings show that DIAPH1 interacts with multiple proteins in H295R human adrenocortical cells and that cAMP signaling modulates the interaction of a subset of proteins with DIAPH1 PMID: 23325789
- Liprin-alpha negatively regulates the activity of mDia in the cell by displacing it from the plasma membrane through binding to the N-terminal Dia-inhibitory domain (DID) and dimerization domain (DD) of mDia PMID: 22266902
- mDia1 knockdown results in Cav1/caveolae clustering and defective inward trafficking upon loss of cell adhesion. PMID: 22454521
- mDia1 and WAVE2 are important Src homology 3 domain partners of IRSp53 in forming filopodia. PMID: 22179776
- a novel mechanism through which an extracellular signal initiated by RAGE ligands regulates RAGE signaling in a manner requiring mDia1. PMID: 22194616
- mDia1 regulates Golgi architecture and dynamics in a Rho-dependent manner PMID: 21680709
- PI3-kinase regulates the thrombin-induced actin cytoskeleton reconstitution in platelets by the RhoA-mDia1 pathway. PMID: 20030946
- Data show that expression of a dominant-negative RhoA mutant or silencing DIAPH1 impaired mitochondrial trafficking and cortisol biosynthesis. PMID: 20591975
- Fli-I promotes the GTP-bound active Rho-mediated relief of the autoinhibition of Daam1 and mDia1. Thus, Fli-I is a novel positive regulator of Rho-induced linear actin assembly mediated by DRFs. PMID: 20223827
- mDia plays an important role in the development of force-induced transcriptional activation of SMA and myofibroblast differentiation PMID: 20071339
- loss of hDia1 did not disrupt actin assembly at the lytic synapse. Instead, loss of hDia1 led to perturbations in the microtubule cytoskeleton, including the targeting of microtubules to the lytic synapse PMID: 19913427
- ROCK and Dia have opposing effects on adherens junctions downstream of Rho. PMID: 11992112
- mDia influences Pax6-induced transcriptional activity and axonal pathfinding in a way opposite from ROCK (Rho kinase) and that it may act via Pax6 to modulate early neuronal development PMID: 12324464
- mDia is present in very small amounts in freshly isolated peripheral blood lymphocytes, is induced in vivo and in vitro during T cell activation, and is involved in regulating the F-actin/G-actin balance critical for T cell motility. PMID: 12847276
- RhoA, mDia, and ROCK have roles in cell shape-dependent control of the Skp2-p27kip1 pathway and the G1/S transition PMID: 15096506
- Results show that mDia1 and PKD2 interact in native and in transfected cells, and binding is mediated by the cytoplasmic C terminus of PKD2 binding to the mDia1 N terminus. PMID: 15123714
- findings show that in melanomas invasiveness can be regulated epigenetically by the microphthalmia-associated transcription factor, Mitf, by regulation of the DIAPH1 gene; Mitf, via regulation of Dia1, can both inhibit invasiveness & promote proliferation PMID: 17182868
- Increases in GTP-bound RHOA and DIAPH1 expression may contribute to the increase in uterine activity in idiopathic preterm labor. PMID: 17301291
- Data suggest that Dia1 localizes to and controls E-cadherin-mediated junctions in a RhoA-dependent manner. PMID: 17940061
- Angiopoietin 1 promotes the activation of mDia through RhoA, resulting in the association of mDia with Src. [mD1a] PMID: 18194650
顯示更多
收起更多
-
相關疾病:Deafness, autosomal dominant, 1 (DFNA1); Seizures, cortical blindness, and microcephaly syndrome (SCBMS)
-
亞細胞定位:Cell membrane. Cell projection, ruffle membrane. Cytoplasm, cytoskeleton. Cytoplasm, cytoskeleton, microtubule organizing center, centrosome. Cytoplasm, cytoskeleton, spindle. Cytoplasm. Nucleus.
-
蛋白家族:Formin homology family, Diaphanous subfamily
-
組織特異性:Expressed in brain, heart, placenta, lung, kidney, pancreas, liver, skeletal muscle and cochlea. Expressed in platelets.
-
數據庫鏈接:
Most popular with customers
-
-
YWHAB Recombinant Monoclonal Antibody
Applications: ELISA, WB, IHC, IF, FC
Species Reactivity: Human, Mouse, Rat
-
-
-
-
-
-